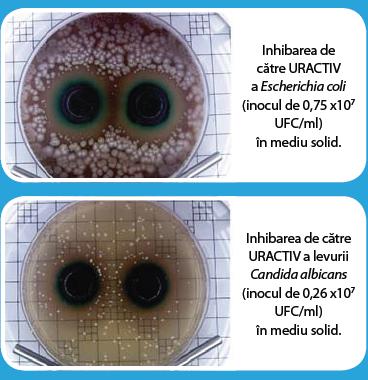

Infecţia urinară este una din condițiile patologice frecvente, întâlnită cu incidență mai mare la femei, datorită particularităţilor anatomice, în special vecinătatea între orificiul urinar și anus.
• 50% dintre femei suferă cel puţin o dată în viaţă de o formă de infecţie urinară, agentul patogen cel mai frecvent implicat fiind bacteria Escherichia coli, responsabilă de producerea a 85% din infecții.
Pentru prevenirea și tratarea infecțiilor urinare, Fiterman Pharma a creat gama Uractiv: capsule și plicuri.
• Uractiv capsule conține extract de strugurii ursului (Arctosta-phylos uva ursi) standardizat în arbutină 20% şi albastru de metilen (Methylthioninium Chloride).
• Uractiv Drink conţine: extract de strugurii ursului (Arctostaphylos Uva Ursi) standardizat în arbutină 20%, extract uscat din rizomi de pir (Agropyron repens), ulei esenţial de anason stelat purificat (Illicium verum), și ulei esenţial de mentă (Mentha piperita).
• Uractiv este indicat în tratamentul afecţiunilor inflamatorii moderate şi uşoare ale tractului urinar inferior: cistite, uretrite, în prevenirea infecţiilor urinare recidivante, în prevenirea extinderii infecţiei la nivelul tractului urinar superior precum şi a complicaţiilor, în tratamentul microlitiazei renale.
Uractiv acționează ca un bactericid, antiinflamator şi diuretic. Prin cumulul acțiunilor principiilor active se realizează diminuarea rapidă a simptomatologiei.
Rezultatele testelor de laborator au arătat că URACTIV are acţiune bactericidă împotriva Escherichia coli, dar și asupra levurii Candida albicans.
CUM ACȚIONEAZĂ URACTIV
- Calmează durerile și iritațiile de la urinare
- Distruge și elimină bacteriile responsabile de infecția urinară
- Elimină microcalculii și previne formarea litiazei urinare
- Limpezește urina și reduce mirosul neplăcut datorat infecțiilor
- Previne recidivele și complicațiile
- Colorează urina în albastru datorită albastrului de metilen
- Reduce retenția de apă.